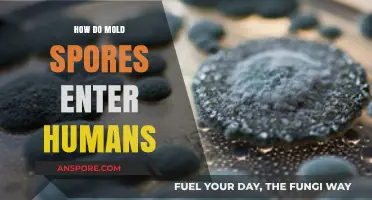
Understanding Mold Spore Inhalation: How They Enter and Affect Humans

Mold spores are microscopic, seed-like structures produced by fungi as part of their reproductive cycle. They form through a process called sporulation, which occurs when mold colonies mature under favorable conditions, such as high humidity, warmth, and organic matter for nourishment. Molds typically produce spores in specialized structures like conidiophores or sporangia, depending on the species. These spores are lightweight and easily become airborne, allowing them to disperse widely and colonize new environments. Once released, they can remain dormant for extended periods until they land in a suitable habitat with adequate moisture and nutrients, where they germinate and grow into new mold colonies. Understanding how mold spores form is crucial for preventing mold growth and mitigating its health and structural impacts.
| Characteristics | Values |
|---|---|
| Formation Process | Mold spores form through a process called sporulation, which is part of the fungal reproductive cycle. |
| Type of Reproduction | Primarily asexual (via mitosis), though some molds can also reproduce sexually. |
| Structure | Spores are single-celled, lightweight, and often hydrophobic, allowing them to survive in various environments. |
| Location of Formation | Spores develop on specialized structures like hyphae (filaments) or sporangia (spore-bearing structures). |
| Environmental Triggers | Sporulation is triggered by nutrient depletion, stress, or changes in environmental conditions (e.g., humidity, temperature). |
| Dispersal Mechanism | Spores are dispersed through air, water, or physical contact, aided by their small size and lightweight nature. |
| Survival Capabilities | Highly resilient, capable of surviving extreme conditions (e.g., drought, heat, cold) for extended periods. |
| Size | Typically 2–10 micrometers in diameter, making them invisible to the naked eye. |
| Shape | Varies by species (e.g., spherical, oval, or elongated). |
| Color | Ranges from colorless to green, black, brown, or other hues depending on the mold species. |
| Lifespan | Can remain viable for years under favorable conditions. |
| Health Impact | Can cause allergies, respiratory issues, or infections in humans and animals when inhaled or contacted. |
| Ecological Role | Play a crucial role in decomposing organic matter and nutrient cycling in ecosystems. |
Explore related products
What You'll Learn
- Sporulation Conditions: Mold spores form under stress like nutrient depletion, pH changes, or temperature shifts
- Hyphal Growth: Mold develops filamentous structures called hyphae, which produce spore-bearing structures
- Spore Types: Molds create asexual spores (conidia) or sexual spores (zygotes, ascospores, basidiospores)
- Dispersal Mechanisms: Spores are released via wind, water, or physical disturbance for widespread colonization
- Environmental Triggers: Factors like humidity, light, and surface type influence spore formation and release

Sporulation Conditions: Mold spores form under stress like nutrient depletion, pH changes, or temperature shifts
Mold spores are not a sign of a fungus living its best life; they’re a survival tactic born from adversity. When conditions turn harsh—nutrients run low, pH levels swing, or temperatures veer outside the comfort zone—mold switches gears. Sporulation is its last-ditch effort to persist, a microscopic Hail Mary triggered by environmental stress. This isn’t random; it’s a calculated response, a biological gamble to ensure the species’ continuity when the current habitat becomes untenable.
Consider nutrient depletion, the most common trigger. When food sources dwindle, mold colonies face starvation. In response, certain species, like *Aspergillus* and *Penicillium*, redirect energy from growth to spore production. These spores are lightweight, resilient, and designed for dispersal, capable of lying dormant until they land in a more hospitable environment. For instance, in a laboratory setting, researchers often induce sporulation by reducing agar nutrient concentrations by 50–70%, mimicking the scarcity mold encounters in nature.
PH shifts are another stressor that forces mold into sporulation mode. Fungi thrive in slightly acidic to neutral conditions (pH 5–7), but deviations outside this range disrupt metabolic processes. A sudden drop to pH 4 or spike to pH 8 can halt vegetative growth, prompting spore formation as a defensive measure. Baker’s yeast, for example, sporulates when exposed to acetic acid (pH 3), a phenomenon exploited in food preservation to inhibit mold growth in acidic products like pickles or vinegar-based sauces.
Temperature fluctuations are equally disruptive. Most molds prefer mesophilic conditions (20–30°C), but extremes—whether a chill below 10°C or a heatwave above 40°C—can trigger sporulation. Cold stress, in particular, induces spore formation in species like *Cladosporium*, which often appears on damp walls in unheated buildings during winter. Conversely, heat stress prompts *Fusarium* species to sporulate, a concern in grain storage facilities where temperatures rise during summer.
Understanding these sporulation conditions isn’t just academic—it’s practical. For homeowners, maintaining stable indoor conditions (humidity below 60%, temperature between 18–24°C) can prevent the stress that drives mold to sporulate. In industrial settings, controlling pH and nutrient levels in food processing equipment reduces the risk of contamination. Even gardeners can benefit: rotating crops annually depletes soil nutrients unevenly, discouraging mold from establishing persistent spore reservoirs.
The takeaway? Mold spores aren’t a sign of strength but a response to weakness. By manipulating the stressors that trigger sporulation—nutrient availability, pH, and temperature—we can disrupt the fungus’s survival strategy. Whether you’re preserving food, maintaining a home, or cultivating crops, recognizing these conditions empowers you to outsmart mold at its own game.
Pasteurization and Botulism: Does Heat Treatment Eliminate Deadly Spores?
You may want to see also

Hyphal Growth: Mold develops filamentous structures called hyphae, which produce spore-bearing structures
Mold, a ubiquitous fungus, initiates its life cycle through a fascinating process centered on hyphal growth. These filamentous structures, known as hyphae, are the building blocks of mold colonies. Imagine a network of microscopic threads, each one a hypha, spreading across a surface in search of nutrients. This growth is not random but a strategic expansion, allowing mold to colonize new areas efficiently. The hyphae's primary role is to absorb nutrients from the environment, but their significance goes beyond mere sustenance.
As hyphae mature, they give rise to specialized structures, the spore-bearing organs, which are the factories of mold reproduction. These structures, often visible as fuzzy or powdery growths, are where the magic of spore formation happens. The process is akin to a biological assembly line, with each hypha contributing to the production of countless spores. For instance, in the common household mold *Aspergillus*, the hyphae develop into structures called conidiophores, which bear chains of spores, or conidia, ready to be dispersed.
The formation of spores is a critical survival strategy for mold. These lightweight, resilient structures are designed for dispersal, allowing mold to travel through air currents and colonize new environments. Each spore is a potential new mold colony, equipped with the genetic material and nutrients needed to initiate growth upon finding a suitable habitat. This dispersal mechanism ensures the species' survival and explains why mold can appear almost anywhere, from damp walls to spoiled food.
Understanding hyphal growth and spore formation is not just a biological curiosity; it has practical implications. For instance, in the food industry, controlling mold growth is essential to prevent spoilage. By inhibiting hyphal development, either through environmental control or antimicrobial agents, the production of spores can be mitigated, thus extending the shelf life of perishable goods. Similarly, in indoor environments, managing moisture levels can disrupt the hyphal growth process, preventing the formation of spore-bearing structures and reducing the risk of mold-related health issues.
In summary, hyphal growth is the cornerstone of mold's reproductive strategy. These filamentous structures not only facilitate nutrient absorption but also give rise to spore-bearing organs, ensuring the fungus's proliferation. By studying this process, we gain insights into mold's resilience and adaptability, knowledge that can be applied to various fields, from food preservation to indoor air quality management. This understanding empowers us to control and prevent mold growth, safeguarding both our health and the integrity of various materials and environments.
How to Obtain Spore Blossoms in Minecraft Survival Mode
You may want to see also

Spore Types: Molds create asexual spores (conidia) or sexual spores (zygotes, ascospores, basidiospores)
Mold spores are the microscopic units of reproduction that enable fungi to spread and survive in diverse environments. Among the myriad of spore types, molds primarily produce two categories: asexual spores, known as conidia, and sexual spores, which include zygotes, ascospores, and basidiospores. Each type serves distinct purposes in the mold's life cycle, ensuring their persistence across varying conditions. Understanding these spore types is crucial for anyone dealing with mold prevention, remediation, or research.
Asexual Spores (Conidia): The Rapid Reproducers
Conidia are the most common type of mold spores and are produced through asexual reproduction. They form at the ends of specialized structures called conidiophores, which are often visible under a microscope as branching, tree-like formations. Conidia are lightweight and easily dispersed through air, water, or physical contact, making them highly effective at colonizing new environments. For instance, a single mold colony can release millions of conidia daily, which can remain dormant for years until favorable conditions trigger germination. Practical tip: Regularly inspect damp areas like bathrooms and basements, as conidia thrive in moisture-rich environments. Reducing humidity below 60% can inhibit their growth and spread.
Sexual Spores: The Survival Specialists
Unlike conidia, sexual spores are formed through the fusion of compatible hyphae, resulting in zygotes, ascospores, or basidiospores. These spores are thicker-walled and more resilient, allowing them to withstand harsh conditions such as extreme temperatures, dryness, or chemical exposure. For example, ascospores, produced within sac-like structures called asci, are common in molds like *Aspergillus* and *Penicillium*. Basidiospores, found in mushrooms and some molds, are released from club-shaped structures called basidia. While sexual spores are less common than conidia, their durability makes them critical for long-term survival. Caution: Sexual spores can remain viable for decades, so thorough remediation is essential when dealing with mold infestations.
Comparative Analysis: Conidia vs. Sexual Spores
The distinction between asexual and sexual spores lies in their function and structure. Conidia are the mold's primary means of rapid colonization, optimized for quick dispersal and immediate growth. In contrast, sexual spores act as a survival mechanism, ensuring genetic diversity and long-term persistence. For instance, conidia are more likely to cause allergic reactions due to their sheer numbers and airborne nature, while sexual spores are less frequently encountered but pose risks in compromised environments, such as hospitals or food storage facilities. Takeaway: Tailoring mold control strategies to target both spore types is essential for effective prevention and remediation.
Practical Tips for Managing Spore Types
To mitigate the spread of conidia, focus on moisture control and regular cleaning of susceptible areas. Use HEPA filters to capture airborne spores and avoid disturbing moldy materials without proper protective equipment. For sexual spores, thorough removal of mold-infested materials is critical, as their resilience makes them harder to eliminate. In severe cases, professional remediation may be necessary to ensure complete eradication. Example: After a flood, dry affected areas within 24–48 hours to prevent conidia from germinating, and inspect for hidden mold colonies that could produce sexual spores over time.
By understanding the unique characteristics of asexual and sexual spores, individuals can adopt targeted strategies to control mold growth and protect their health and property. Whether dealing with a minor infestation or a large-scale remediation, knowledge of spore types is a powerful tool in the fight against mold.
Can Washing Machines Kill Mold Spores? Facts and Tips Revealed
You may want to see also
Explore related products

Dispersal Mechanisms: Spores are released via wind, water, or physical disturbance for widespread colonization
Mold spores are nature's microscopic travelers, equipped with an arsenal of dispersal mechanisms to ensure their survival and proliferation. Among these, wind, water, and physical disturbance stand out as the primary vectors for their journey to new habitats. Wind, the most ubiquitous of these, carries spores aloft in currents that can transport them across continents. Lightweight and aerodynamic, mold spores are perfectly adapted for aerial dispersal, often traveling hundreds of miles before settling on a suitable substrate. This mechanism is particularly effective for outdoor molds, such as those found in soil or decaying vegetation, where open spaces facilitate their airborne journey.
Water, another critical dispersal agent, plays a dual role in spore dissemination. Raindrops dislodge spores from their parent structures, splashing them onto nearby surfaces or into water bodies, where they can be carried downstream. This method is especially prevalent in humid environments, where moisture is abundant. For instance, *Aspergillus* and *Penicillium* spores thrive in damp conditions, using water as a conduit to infiltrate homes through leaks or flooded areas. Additionally, indoor plumbing systems can inadvertently become highways for mold spores, spreading them through pipes and drains if not properly maintained.
Physical disturbance, often overlooked, is a potent mechanism for spore release in both natural and human-altered environments. Walking through a mold-infested area, vacuuming carpets, or even handling contaminated materials can dislodge spores, propelling them into the air. This is particularly concerning in indoor settings, where disturbed spores can quickly colonize new surfaces if conditions are favorable. For example, construction activities in water-damaged buildings often exacerbate mold problems by agitating dormant spores, leading to widespread contamination.
To mitigate the spread of mold spores, practical measures must be tailored to their dispersal mechanisms. In wind-prone areas, sealing windows and using HEPA filters can reduce indoor spore infiltration. Water-related dispersal can be controlled by promptly addressing leaks, maintaining proper drainage, and using dehumidifiers in moisture-prone spaces. For physical disturbance, containment is key: isolate moldy areas during remediation, use damp methods to clean surfaces, and wear protective gear to avoid becoming a vector yourself. By understanding these mechanisms, we can disrupt the lifecycle of mold spores and prevent their colonization in unwanted areas.
Mold Spores and Sinus Infections: Uncovering the Hidden Connection
You may want to see also

Environmental Triggers: Factors like humidity, light, and surface type influence spore formation and release
Mold spores are nature's microscopic opportunists, lying dormant until environmental conditions awaken their reproductive drive. Among the key triggers, humidity stands out as a critical factor. Mold thrives in environments where relative humidity exceeds 60%, as water vapor provides the moisture necessary for spore germination and growth. For instance, bathrooms and basements, often damp and poorly ventilated, become breeding grounds for mold. To mitigate this, maintain indoor humidity below 50% using dehumidifiers or air conditioners, especially in climates prone to high moisture levels. Regularly monitor humidity with a hygrometer, ensuring readings stay within the optimal range to stifle spore formation.
Light, though less intuitive, also plays a subtle yet significant role in mold spore dynamics. While mold doesn't photosynthesize like plants, certain species exhibit phototropism, growing toward or away from light sources. UV light, in particular, can inhibit spore formation by damaging mold's cellular structure, which is why sunlit areas often have lower mold prevalence. However, prolonged exposure to artificial light, especially in dark, enclosed spaces, can inadvertently create temperature fluctuations that foster mold growth. To harness light's benefits, allow natural sunlight into rooms whenever possible, and use UV-C lamps in areas like HVAC systems to reduce spore counts without relying on chemicals.
Surface type acts as a silent mediator in the mold spore narrative, dictating where and how spores adhere and proliferate. Porous materials like drywall, wood, and fabric provide ideal habitats for mold, as their microscopic crevices trap moisture and nutrients. In contrast, non-porous surfaces like glass, metal, and sealed concrete resist spore attachment, making them less susceptible to colonization. When renovating or designing spaces, opt for mold-resistant materials such as mold-inhibiting paints or treated wood. For existing surfaces, apply antimicrobial coatings to high-risk areas like shower walls and kitchen backsplashes, reducing the likelihood of spore establishment.
The interplay of these environmental triggers underscores the importance of holistic mold prevention strategies. For example, in a humid basement with concrete walls and minimal light, installing a dehumidifier, painting walls with mold-resistant coatings, and strategically placing UV lamps can create an inhospitable environment for spores. Conversely, neglecting any one factor—such as reducing humidity without addressing porous surfaces—leaves room for mold to exploit weaknesses. By understanding and manipulating these triggers, individuals can proactively disrupt the mold lifecycle, safeguarding both health and property from the insidious spread of spores.
Applying Milky Spore Before Rain: Timing Tips for Effective Lawn Treatment
You may want to see also
Frequently asked questions
Mold spores form in environments with moisture, warmth, and organic matter. High humidity (above 60%), temperatures between 68°F and 86°F (20°C and 30°C), and materials like wood, paper, or fabric provide ideal conditions for spore development.
Mold spores spread through the air, water, or physical contact. They are lightweight and can travel long distances via air currents, attach to clothing or pets, or be carried by water droplets, allowing them to colonize new areas.
Yes, mold spores can exist without visible mold growth. Spores are microscopic and can remain dormant in the environment until conditions become favorable for them to germinate and grow into visible mold colonies.
Mold spores can begin to form within 24 to 48 hours after moisture exposure, depending on the material and environmental conditions. Visible mold growth typically appears within 1 to 2 weeks under optimal conditions.